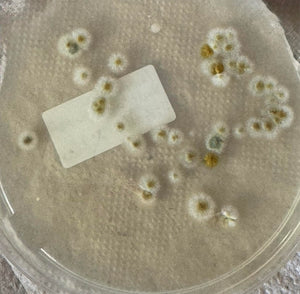

Simply follow the easy instructions included. Place the test plates where you suspect mold, and use the detailed guide to identify mold types.

Home Mold Detection Kit
Easily detect and identify mold to ensure a healthier home environment.
✅ Detect Mold Early in multiple areas for safety.
✅ Improve Air Quality by identifying spores quickly.
✅ Gain Peace of Mind with accurate mold results.
✅ Save Money by addressing issues before they escalate.


Struggling with Hidden Mold?
Discovering hidden mold can be tricky, but this kit makes it simple. Quickly test various areas in your home, like bathrooms and basements, for peace of mind and a healthier environment.
Breathe Easier with Mold-Free Air
This kit empowers you to detect, identify, and tackle mold, ensuring your home remains a safe space. Experience the relief of knowing your environment is healthier and mold-free.


Worried About Indoor Air Quality?
Indoor air can harbor invisible mold spores that affect your health. This kit helps you identify and address these hidden threats, ensuring you breathe easier at home.
Why Choose Home Mold Detection Kit?
This kit stands out with its comprehensive testing, user-friendly design, and detailed guides, providing peace of mind and a healthier home environment. Others lack these combined benefits.

Experience a Healthier, Mold-Free Home
Get Answers About Your Mold Testing Kit
Clarity and support for a seamless mold testing experience.
How do I use the mold test kit effectively?
Can this kit detect airborne mold?
Yes, it tests both surfaces and air quality to ensure your home is free from harmful mold spores.
What if I can't identify the mold type?
Send pictures of the mold to our experts. They'll provide assistance and help you understand the results.
Is this kit reusable for multiple tests?
Yes, it includes multiple test plates and swabs, allowing you to test different areas or retest after removal.
How soon will I see results?
You'll typically get results within a few days, so you can quickly take action if needed.
What Customers Are Saying: Mold Test Kit
Risk-Free 30-Day Trial with Home Mold Detection Kit
Experience the peace of mind that comes with knowing your home is mold-free. With a 30-day money-back guarantee, you can try our mold detection kit risk-free. If you're not satisfied, return it for a full refund. Ensure a safer, healthier living space without worry.







